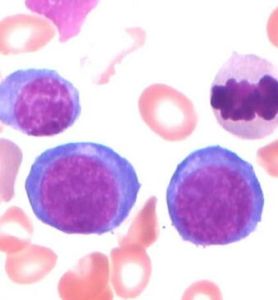
急性造血功能停滯 急性造血功能停滯

基本內容
急性造血停滯(AAH),又稱急性再障危象。本病是在原有慢性貧血或其他疾病的基礎上,在某些誘因作用下,促使造血功能紊亂和代償失調,血細胞暫時性減少或缺如,一旦誘因去除,危象也可隨之消失。常見的原發病有各種遺傳性慢性溶貧、營養型貧血,或在其他原發病基礎上,又患感染(如上感或肺炎)、多種營養素缺乏和免疫調節紊亂。也可因服用某些藥物影響了DNA的合成而致發病。
⑴血象:①貧血比原有疾病嚴重,多為重度貧血,Ret極度減低甚至不見,恢復期可見上升。②白細胞數可正常,淋巴占絕大多數,可見異淋,中性粒有中毒顆粒和空泡變性。③血小板一般正常。誘因去除後,以上血象可逐漸恢復,先是Ret和粒細胞上升,Hb則恢復較慢。
⑵骨髓象:①多增生活躍或明顯活躍,但也有的減低。②幼紅細胞嚴重減少或消失,粒紅比增大,以出現巨大原紅為特徵,胞體呈圓形或橢圓形,20~50μm,有少量灰藍色胞漿內含藍色顆粒,,出現空泡及中毒顆粒,周邊有鈍偽足,染色質細緻網點狀,核仁1~2個,隱顯不一。②粒系由於幼紅細胞嚴重減少,而呈相對性增多,可見核左移、中毒顆粒核空泡變性。③巨核系大致正常。